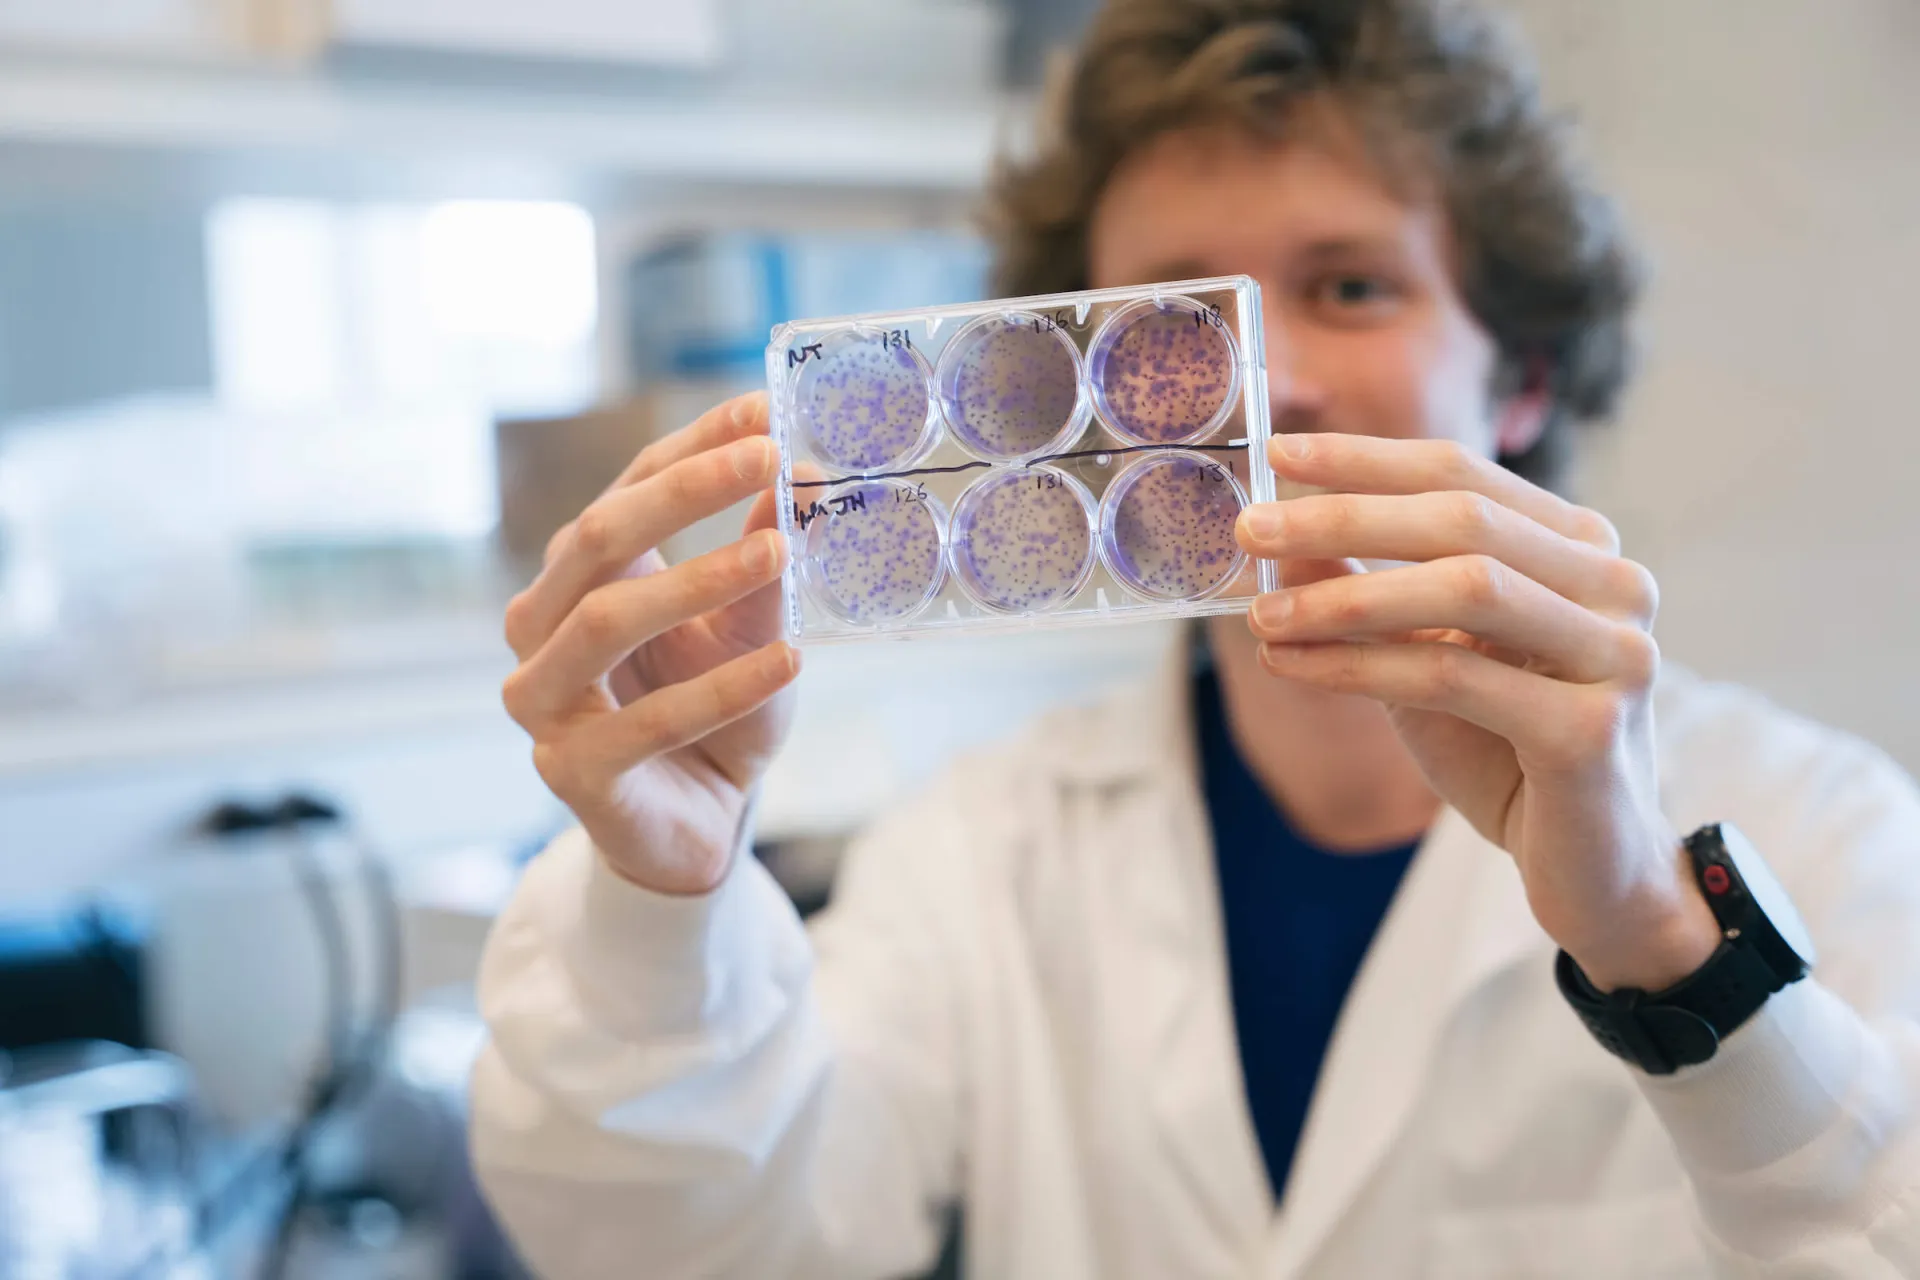

What is NSF I-Corps?
The U.S. National Science Foundation’s Innovation Corps (I-Corps™) is an entrepreneurial training program for STEM researchers that facilitates the transformation of invention into impact. This immersive, seven-week experiential training program prepares scientists and engineers to extend their focus beyond the university laboratory — accelerating the economic and societal benefits of research projects ready to move toward commercialization.
How to Get Involved
The University of Vermont is a proud partner of the NSF Interior Northeast Innovation Corps Hub (IN I-Corps), aiming to support students, faculty, and researchers in accelerating their discoveries from lab to market.
Through the IN I-Corps Hub, UVM students, faculty, and researchers have access to intellectual and entrepreneurial tools and resources across universities, including:
- Free regional entrepreneurship courses
- Access to the Hub's robust entrepreneurial network
- Support in applying for NSF's I-Corps teams ($50,000 award)
- Accelerate SBIR/STTR grant applications ($275,000+ award)